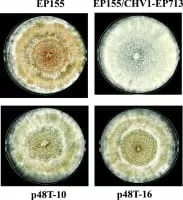

Hypovirus
| Use attributes for filter ! | |
| Rank | Genus |
|---|---|
| Higher classification | Hypoviridae |
| Date of Reg. | |
| Date of Upd. | |
| ID | 2267645 |
About Hypovirus
Hypovirus is a genus of viruses, in the family Hypoviridae. Fungi serve as natural hosts. There are currently four species in this genus including the type species Cryphonectria hypovirus 1. Diseases associated with this genus include: host virulence reduction.